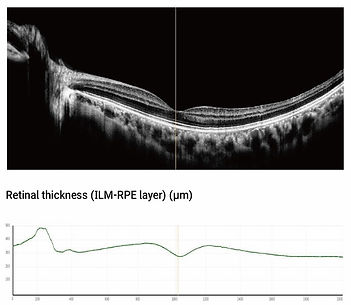

OCT
BV-1000S

Inteligencia artificial OCT totalmente automatizada de nueva generación
Una nueva generación de inteligencia artificial OCT totalmente automatizada
(segmento anterior y posterior)
Tomógrafo de coherencia óptica
El tomógrafo de coherencia óptica (OCT) oftálmico BV1000S es un OCT de inteligencia artificial totalmente automático con derechos de propiedad intelectual. Combinado con tecnología de registro multiimagen y mejora de imágenes, y tecnología de análisis líder en la industria, proporciona una solución integral para el diagnóstico y el tratamiento clínico, que incluye captura automática de imágenes, análisis preciso de imágenes, gestión inteligente de registros de salud ocular e intercambio de datos en tiempo real en la nube



Adquisición ultrarrápida de la señal del fondo de ojo
Tecnología de aceleración de 80.000 veces por segundo, la velocidad de escaneo mejora enormemente, lo que ayuda a capturar con precisión diferentes formas de subdivisión de las lesiones del fondo de ojo en menos tiempo y a obtener imágenes de alta calidad

Imágenes hiperfinas de la estructura del fondo de ojo
El algoritmo de análisis de imágenes oftálmicas multimodales de IA basado en el aprendizaje profundo puede observar con mayor precisión la morfología de subdivisión de diversas enfermedades del fondo de ojo y el desarrollo de lesiones en diferentes capas estructurales de la retina, obtener imágenes jerárquicas de la retina y la coroides, apoyar la monitorización, el diagnóstico y el análisis jerárquico de la enfermedad, y ayudar a los médicos a encontrar más evidencia de la enfermedad para los pacientes y guiar el tratamiento

Imágenes por capas de la retina y la coroides en modo de estratificación automática
El grosor de la coroides retiniana del fondo de ojo se puede cuantificar

Diseño ultra portátil y humanizado
El OCT ergonómico de inteligencia artificial suave y dura totalmente automático ofrece a los usuarios una nueva experiencia de equipo totalmente automático.
Adopta el diseño dividido de host óptico y pantalla, combinando un excelente diseño óptico, un algoritmo automático, un marco de computación paralela de alta velocidad y una interfaz de interacción persona-computadora muy fácil de usar. La calidad de las imágenes, la precisión del análisis, la velocidad de cálculo y la comodidad de operación se han mejorado enormemente
Función de análisis de campo amplio
Escaneo de campo amplio (12 mm x 9 mm)
Al cubrir el área macular y el área del disco óptico al mismo tiempo, se puede detectar completamente la enfermedad de la retina

Análisis de software
Mapa del fondo de ojo de 12 x 9 mm, Grosor coroideo promedio
Grosor foveal macular, Mapa de cuadrícula del grosor TSNI de la capa de fibras nerviosas, Volumen retiniano total, Grosor circular de la capa de fibras nerviosas de la retina (RNFL), Grosor retiniano promedio, Mapa de cuadrícula del grosor macular, ILM-RPE de 6 x 6 mm, Mapa topográfico del grosor de la RNFL, Topograma del grosor ILM-RPE, Mapa de cuadrícula del grosor macular ILM-OPL de 6 x 6 mm, Mapa topográfico del grosor BRM-SCL, Mapa topográfico del grosor ILM-OPL y Mallas del grosor macular BRM-SCL de 6 x 6 mm

Escaneo de una sola línea de alta definición
Escaneo de seis líneas radiales

Función de análisis de glaucoma
Área del disco
-
Análisis de software
-
Mapa del fondo del disco óptico de 6 x 6 mm
-
Relación cotilo-disco
-
Relación cotilo-disco horizontal
-
Relación cotilo-placa vertical
-
Área de la cotilometría óptica
-
Curva del espesor del borde de la capa de fibras nerviosas de la retina
-
Mapa topográfico del espesor de la capa de fibras nerviosas de la retina
-
Mapa de cuadrícula del espesor de la capa de fibras nerviosas de la retina (TSNI)
El área macular
Análisis de software
-
Mapa del fondo de ojo de 6 x 6 mm de la mácula
-
Grosor promedio de la retina interna
-
Grosor promedio de la retina
-
Grosor foveal macular
-
Topografía del grosor de la MLI-EPR
-
Mapa de cuadrícula del grosor de la MLI-EPR
-
Mapa topográfico del grosor de la capa de fibras nerviosas de la retina
-
Mapa de cuadrícula del volumen retiniano



Función de análisis del segmento anterior
Escaneo de una sola línea de alta definición del segmento anterior
Escaneo de seis líneas radiales del segmento anterior
Diagrama de la lesión
Se puede utilizar para el diagnóstico auxiliar de 16 enfermedades principales del fondo de ojo

Agujero macular
El agujero macular es una pérdida de tejido de toda la capa o parte de la retina del nervio macular. La mayoría de ellos son idiopáticos y están relacionados con una tracción vítreomacular anormal, y algunos están relacionados con un traumatismo. El agujero macular lamelar (AML) es una capa de pérdida de tejido en la superficie de la fóvea y a menudo se asocia con la membrana epirretiniana


Líquido subretiniano
En la OCT, se observó un desprendimiento seroso debajo de la capa neuroepitelial de la retina, con hiporreflexión uniforme dentro del área de desprendimiento y una zona de reflexión de luz continua en la capa del epitelio pigmentario de la retina debajo

INFORME DEL EXAMEN
Informe de análisis de los binoculares OCT BV1000S
Parámetros técnicos

Modos de escaneo

Nota: Al seleccionar el modo de segmento anterior, los dispositivos periféricos del segmento anterior deben estar en su lugar; el diseño y los parámetros están sujetos a cambios sin previo aviso.
